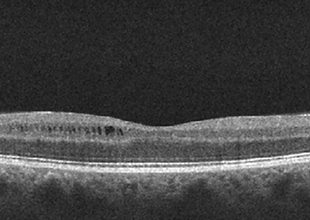
Neuro-Ophthalmology 15-2.png
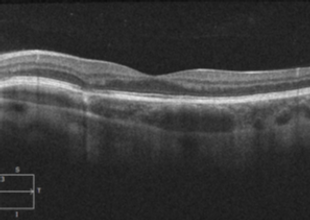
Uveitis8_6.png

top of page
Patient Presentation: A 23-year-old obese female was diagnosed with idiopathic intracranial hypertension (IIH) and referred to neurosurgery for ventriculoperitoneal shunt. A baseline ocular examination was performed prior to the procedure.
On examination, vision was 20/200 in the right eye, and 20/40 in the left eye. There was a right relative afferent pupillary defect. Slit lamp examination was normal.
A dilated fundus examination was performed demonstrating the following:
OCTcases Atlas
Welcome to the OCTcases Atlas! This page will allow you to search for high-yield OCT images through a centralized database. Clicking the OCT image below will take you to the practice case pertaining to that disease to allow you to consolidate your knowledge.
All OCT images on this website are copyrighted by OCTcases.com. No text, images, data, or videos may be copied from this website without our written permission. Any violations will be prosecuted to the full extent of the law.
If you are eager for more practice at quickly interpreting OCT images, we recommend the free OCT practice modules from our partners at Eyeguru.com.
bottom of page
.png)

.png)




